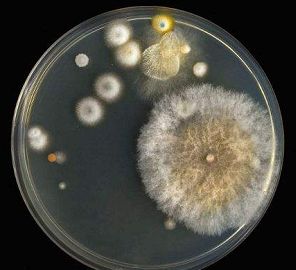
菌落超标的零食为啥不下架,哪些零食食品超标

东南产经网
有内涵的时政、财经
社会新媒体
出事了!
大多数人爱吃的这款零食
霉菌超标34倍多!
被令下架召回!
它就是
▼
正林红瓜子
目前该不合格食品
已被依法查处

华润万家销售的这款瓜子
霉菌超标34倍多
可能腐败变质
不少人都吃过
正林红瓜子
▼
3月25日,广东省市场监督管理局发发布了关于2批次食品不合格情况的通告。通告显示,一批次红瓜子霉菌超标,另一批次食用盐碘项目不合格,经核实该样品为假冒产品。针对抽检中发现的不合格食品,广东省市场监督管理局要求各级市场监管部门依法予以查处。
监督抽检不合格产品信息

这款正林红瓜子
霉菌超标34倍多

此次炒货食品及坚果制品抽检项目包括铅(以Pb计)、酸价(以脂肪计)等10项。一批次由华润万家生活超市(广州)有限公司清远清新店销售、广州市伯荣食品有限公司生产的320克/袋型号的正林红瓜子,霉菌检出值为890CFU/g,在最高限值25CFU/g的标准规定下,该批次瓜子霉菌超标34倍多。
霉菌超标或致癌
吃多了可能急性中毒
据了解,霉菌是自然界中常见的真菌。
食品中霉菌超标原因可能是加工用原料受霉菌污染,或者是产品存储、运输条件控制不当导致流通环节抽取的样品被霉菌污染。霉菌污染可使食品腐败变质,破坏食品的色、香、味,降低食品的食用价值。
通常霉菌超标,都与企业储存、运输不当有关。专家介绍,霉菌超标的坚果,不仅容易腐败变质,还易产生毒素,过量食用可能致癌,或导致急性中毒。
在淘宝正林食品旗舰店上
该问题样品没有在售
记者搜索发现,在淘宝正林食品旗舰店内,该问题样品没有在售。店内客服表示,店铺对抽检不合格一事不知情,表示此前店内也没有销售过该批次产品。

记者梳理发现,生产公司广州市伯荣食品有限公司不是第一次上榜,2017年12月29日,广州市食药监局官网发布抽检信息称,标示为广州市伯荣食品有限公司2017年8月1日生产,规格为200克/包的家乐蒜香味花生,大肠菌群项目检出不合格,该样品大肠菌群5次检出值分别为15CFU/g,250CFU/g,860CFU/g,630CFU/g,52CFU/g,超过标准规定(5次检出值均不得超过100CFU/g,且至少3次检出值不超过10CFU/g)。
这些零食常出现的问题
你得注意!
瓜子:注意二氧化硫超标
银耳、开心果、莲子、冰糖、南瓜子等,在加工过程中都会用到硫磺熏蒸,起到漂白和防腐作用,但必须要在规定的剂量内。有些商家为了产品好看,可能会过量添加,导致二氧化硫超标。如果过量、超标使用,长期食用会造成肠道功能紊乱、肝脏损伤,危害人体消化系统。
坚果:注意发苦的可能是发霉了
如果吃到变苦的坚果,一定要及时吐掉并且漱口,因为坚果的苦味正是来自霉变过程中产生的黄曲霉毒素,黄曲霉毒素引发的急性中毒,主要是损害肝脏。

蜜饯话梅:注意甜蜜素超标
甜蜜素属于重要质量项目,是食品生产中常用的添加剂和甜味剂,其甜度是蔗糖的30~40倍。消费者如果经常食用甜蜜素含量超标的食品,就会因摄入过量对人体的肝脏和神经系统造成危害,特别是对代谢排毒能力较弱的老人、孕妇、小孩危害更明显。大家购买要提防较多使用甜蜜素的一些蜜饯、话梅。
此前
福建人爱吃的另一款零食
广澳®梅
就被曝出问题!
福建人爱吃的这款零食,铅超标3倍多!被令下架召回!
国家市场监管总局的一期抽检通报《市场监管总局关于30批次食品不合格情况的通告》显示:永辉超市股份有限公司福建福州首山超市销售的标称广东好味佳食品有限公司生产的广澳®梅,经福建省产品质量检验研究院检验发现,其中铅(以Pb计)不符合食品安全国家标准规定。

食品安全关乎每个人!
绝不能轻视!
希望相关部门加强监管!
来源:东南网
往期精彩回顾
“曹园”,拆!
“曹园”事件始末
诏安县委书记何德发被查
海南龙沐湾:27年升值万倍,却烂尾无人接盘
响水爆炸死亡78人,失联人员全部找到
厦门一副局长从收干股开始沦陷……


点开有惊喜 戳戳戳!